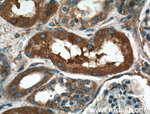
MVP/LRP Antibody in Immunohistochemistry (Paraffin) (IHC (P))

Search
Proteintech
MVP/LRP Polyclonal Antibody
{{$productOrderCtrl.translations['antibody.pdp.commerceCard.promotion.promotions']}}
{{$productOrderCtrl.translations['antibody.pdp.commerceCard.promotion.viewpromo']}}
{{$productOrderCtrl.translations['antibody.pdp.commerceCard.promotion.promocode']}}: {{promo.promoCode}} {{promo.promoTitle}} {{promo.promoDescription}}. {{$productOrderCtrl.translations['antibody.pdp.commerceCard.promotion.learnmore']}}

Please note: We are reviewing Western blot images included in the antibody testing data in our catalog, including those provided by third parties. Unless expressly labeled or annotated as “raw-unedited”, Western blot images included in the antibody testing data in our catalog may have been edited, optimized or otherwise adjusted for presentation.
产品信息
16478-1-AP
种属反应
已发表种属
宿主/亚型
分类
类型
抗原
偶联物
形式
浓度
规格
纯化类型
保存液
内含物
保存条件
运输条件
产品详细信息
Immunogen sequence: NWHFEVNDR KDPQETAKLF SVPDFVGDAC KAIASRVRGA VASVTFDDFH KNSARIIRTA VFGFETSEAK GPDGMALPRP RDQAVFPQNG LVVSSVDVQS VEPVDQRTRD ALQRSVQLAI EITTNSQEAA AKHEAQRLEQ EARGRLERQK ILDQSEAEKA RKELLELEAL SMAVESTGTA KAEAESRAEA ARIEGEGSVL QAKLKAQALA IETEAELQRV QKVRELELVY ARAQLELEVS KAQQLAEVEV KKFKQMTEAI GPSTIRDLAV AGPEMQVKLL QSLGLKSTLI TDGSTPINLF NTAFGLLGMG PEGQPLGRRV ASGPSPGEGI SPQSAQAPQA PGDNHVVPVL R (544-893 aa encoded by BC015623)
靶标信息
This gene encodes the major vault protein which is a lung resistance-related protein. Vaults are multi-subunit structures that may be involved in nucleo-cytoplasmic transport. This protein mediates drug resistance, perhaps via a transport process. It is widely distributed in normal tissues, and overexpressed in multidrug-resistant cancer cells. The protein overexpression is a potentially useful marker of clinical drug resistance. This gene produces two transcripts by using two alternative exon 2 sequences; however, the open reading frames are the same in both transcripts.
仅用于科研。不用于诊断过程。未经明确授权不得转售。
生物信息学
蛋白别名: lrp; Lung resistance-related protein; Major vault protein; MVP; MVP1; Testicular Secretory Protein Li 30; unnamed protein product; VAULT1; vRNP
基因别名: 2310009M24Rik; LRP; MVP; VAULT1
UniProt ID: (Rat) Q62667, (Mouse) Q9EQK5
Entrez Gene ID: (Human) 9961, (Rat) 64681, (Mouse) 78388




